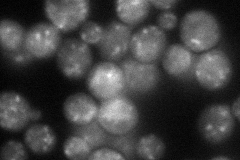
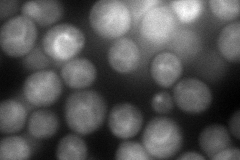
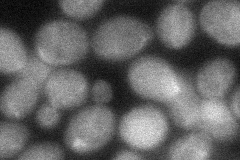

View description
Peripheral membrane protein required for vesicular transport between ER and Golgi and for the 'priming' step in homotypic vacuole fusion, part of the cis-SNARE complex; has similarity to alpha-SNAP
Localization:
Intensity:
Fold change:
Significance:
-
C’ GFP library in SD

below threshold14.64 -
N' NOP1pr-GFP in SD
punctate58.3041 -
N' TEF2pr-mCherry in SD
cytosol,ER162.45 -
N' NATIVEpr-GFP in SD

below threshold17.4155 -
N' TEF2pr-VC and Cyto-VN in SD
cytosol47.7354 -
C’ GFP library in SD+DTT

cytosol14.460.98No -
C’ GFP library in SD+H2O2

cytosol14.030.95No -
C’ GFP library in Starvation Media

cytosol16.71.13No -
C’ GFP library on the background of Pup2-DaMP

below threshold -
C’ GFP library on the background of CCT mutant

below threshold13.16760.898329No
